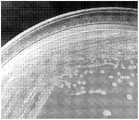

技术领域technical field
本发明属于微生物学领域,具体地,本发明涉及粪厌氧棒杆菌(Anaerostipescaccae)在治疗和预防炎症相关疾病中的应用,也涉及包含粪厌氧棒杆菌的组合物及其应用。The invention belongs to the field of microbiology, in particular, the invention relates to the application of Corynebacterium faecalis (Anaerostipescaccae) in the treatment and prevention of inflammation-related diseases, and also relates to a composition comprising Corynebacterium faecalis and its application.
背景技术Background technique
溃疡性肠炎(UC)是属于炎症性肠病(IBD)的一种,根据炎症部位分为结肠炎和直肠炎,其发病机理尚未清楚,目前主要认为是遗传易感性、肠道菌群、肠粘膜的免疫反应引起的。国内外大量的研究表明,UC的发病与肠道菌群的失衡关系比较密切。UC的临床病理表现为腹痛、腹泻和黏液血便,且反复发作。Ulcerative colitis (UC) is a type of inflammatory bowel disease (IBD), which is divided into colitis and proctitis according to the site of inflammation. mucosal immune response. A large number of studies at home and abroad have shown that the pathogenesis of UC is closely related to the imbalance of intestinal flora. The clinicopathological manifestations of UC are abdominal pain, diarrhea, and mucus and bloody stools, with recurrent episodes.
由于病理机制不明确,临床的治疗也缺乏特异性和针对性,目前,临床上针对UC病的用药主要有水杨酸类、糖皮质激素、免疫制剂。水杨酸类药物可以比较好的抑制前列腺素合成,清除氧自由基从而达到缓解炎症反应的目的,临床上治疗UC常见的水杨酸类西药主要是柳氮磺胺吡啶(SASP),主要针对轻度、中度以及慢性UC患者;糖皮质激素是重症或者爆发性UC患者的首选用药,比如倍他米松;免疫抑制剂如环孢素可以通过抑制T细胞IL-2的产生,影响免疫反应的进展,从而对UC进行抑制。Due to the unclear pathological mechanism and the lack of specificity and pertinence in clinical treatment, at present, the main clinical drugs for UC disease are salicylic acid, glucocorticoid, and immune preparations. Salicylic acid drugs can better inhibit the synthesis of prostaglandins and scavenge oxygen free radicals to achieve the purpose of alleviating the inflammatory reaction. The common salicylic acid western drugs for the clinical treatment of UC are mainly sulfasalazine (SASP), which is mainly aimed at mild symptoms. Patients with severe, moderate and chronic UC; glucocorticoids are the first choice for patients with severe or fulminant UC, such as betamethasone; immunosuppressants such as cyclosporine can inhibit the production of IL-2 in T cells and affect the immune response. progression, thereby suppressing UC.
上述三类药物均可以一定程度上对UC进行缓解,但是也都存在一定的副作用,水杨酸类的副作用是引发消化道反应、头痛、网织红细胞增多、精子减少及过敏反应引起的皮疹、肝毒性、白细胞减少、贫血等。糖皮质激素会导致机体代谢紊乱、水潴留等副作用,仅可作为应急用药,不能长期服用。免疫抑制剂治疗对药物依赖性较大,治疗周期长,容易引起肾毒性及二次感染,只能作为一种辅助治疗的手段。The above three types of drugs can relieve UC to a certain extent, but they also have certain side effects. Hepatotoxicity, leukopenia, anemia, etc. Glucocorticoids can cause side effects such as metabolic disorders and water retention in the body. They can only be used as emergency medicines and cannot be taken for a long time. Immunosuppressive therapy is highly dependent on drugs, has a long treatment period, and is prone to nephrotoxicity and secondary infection, so it can only be used as an adjuvant therapy.
因此本领域迫切需要开发一种的新的,无毒副作用的,用于治疗和预防炎症相关疾病的药物。Therefore, there is an urgent need in the art to develop a new, non-toxic and side-effect drug for the treatment and prevention of inflammation-related diseases.
发明内容SUMMARY OF THE INVENTION
本发明的另一目的是提供粪厌氧棒杆菌在治疗和/或预防炎症相关疾病的用途。Another object of the present invention is to provide the use of Corynebacterium faecalis in the treatment and/or prevention of inflammation-related diseases.
本发明的另一目的是提供一种有效的无毒副作用的,用于治疗和/或预防炎症相关疾病的药品、饮料、食品组合物,或动物饲料组合物。Another object of the present invention is to provide an effective medicine, beverage, food composition, or animal feed composition for treating and/or preventing inflammation-related diseases without toxic and side effects.
本发明的另一目的是提供一种改善哺乳动物肠道病变的方法及其应用。Another object of the present invention is to provide a method for improving mammalian intestinal pathology and its application.
本发明的另一目的是提供一种减缓哺乳动物体重的下降、和/或降低哺乳动物的疾病活动指数(DAI)的方法及其应用。Another object of the present invention is to provide a method of slowing down weight loss in a mammal, and/or reducing the Disease Activity Index (DAI) in a mammal and uses thereof.
本发明第一方面提供了一种粪厌氧棒杆菌,所述粪厌氧棒杆菌为粪厌氧棒杆菌(Anaerostipes caccae),保藏号为GDMCC No.:60088。A first aspect of the present invention provides a Corynebacterium faecalis, the Corynebacterium faecalis is Anaerostipes caccae, and the deposit number is GDMCC No.: 60088.
在另一优选例中,所述的粪厌氧棒杆菌的16s rDNA的序列如SEQ ID NO.:1所示。In another preferred embodiment, the sequence of the 16s rDNA of Corynebacterium faecalis is shown in SEQ ID NO.: 1.
在另一优选例中,所述粪厌氧棒杆菌为Anaerostipes caccae AF04-45。In another preferred embodiment, the Corynebacterium faecalis is Anaerostipes caccae AF04-45.
在另有一优选例中,所述粪厌氧棒杆菌来自肠道、动物粪便、发酵池、和/或厌氧反应器。In another preferred embodiment, the Corynebacterium faecalis comes from the intestinal tract, animal feces, fermentation tanks, and/or anaerobic reactors.
本发明第二方面提供了一种组合物,所述组合物包括:(a)安全有效量的本发明第一方面所述的粪厌氧棒杆菌和/或其代谢产物;以及(b)食品上可接受的载体或药学上可接受的载体。The second aspect of the present invention provides a composition comprising: (a) a safe and effective amount of the Corynebacterium faecalis and/or its metabolites according to the first aspect of the present invention; and (b) food an acceptable carrier or a pharmaceutically acceptable carrier.
在另一优选例中,所述组合物还包括生长因子(较佳地,牛奶生长因子)。In another preferred example, the composition further includes growth factors (preferably, milk growth factors).
在另一优选例中,所述组合物选自下组:食品组合物、保健组合物、药物组合物、饮料组合物、饲料组合物、或其组合。In another preferred example, the composition is selected from the following group: food composition, health care composition, pharmaceutical composition, beverage composition, feed composition, or a combination thereof.
在另一优选例中,所述的组合物为口服制剂。In another preferred embodiment, the composition is an oral preparation.
在另一优选例中,所述的组合物为液态制剂、固态制剂、半固态制剂。In another preferred example, the composition is a liquid preparation, a solid preparation, or a semi-solid preparation.
在另一优选例中,所述的组合物的剂型选自下组:粉末剂、散剂、片剂、糖衣剂、胶囊剂、颗粒剂、悬浮剂、溶液剂、糖浆剂、滴剂、舌下含片、或其组合。In another preferred embodiment, the dosage form of the composition is selected from the following group: powder, powder, tablet, sugar coating, capsule, granule, suspension, solution, syrup, drop, sublingual Lozenges, or a combination thereof.
在另一优选例中,所述的食品组合物包括乳液制品、溶液制品、粉末制品、或悬浮液制品。In another preferred embodiment, the food composition includes an emulsion product, a solution product, a powder product, or a suspension product.
在另一优选例中,所述的食品组合物包括乳品、乳粉、或乳液。In another preferred embodiment, the food composition includes dairy products, milk powder, or emulsion.
在另一优选例中,所述的液态制剂选自下组:溶液制品或悬浮液制品。In another preferred embodiment, the liquid preparation is selected from the following group: a solution product or a suspension product.
在另一优选例中,所述组合物含有1×10-1×1015cfu/mL或cfu/g Anaerostipescaccae AF04-45,较佳地1×104-1×1010cfu/mL或cfu/g Anaerostipes caccae AF04-45,按所述组合物的总体积或总重量计。In another preferred embodiment, the composition contains 1×10-1×1015 cfu/mL or cfu/g Anaerostipescaccae AF04-45, preferably 1×104 -1×1010 cfu/mL or cfu/ g Anaerostipes caccae AF04-45 by total volume or total weight of the composition.
在另一优选例中,所述的组合物中,含有0.0001-99wt%,较佳地0.1-90wt%所述的粪厌氧棒杆菌和/或其代谢产物,以所述组合物的总重量计。In another preferred example, the composition contains 0.0001-99 wt %, preferably 0.1-90 wt % of the Corynebacterium faecalis and/or its metabolites, based on the total weight of the composition count.
在另一优选例中,所述的组合物为单元剂型(一片、一粒胶囊或一小瓶),每个单元剂型中所述组合物的质量为0.05-5g,较佳地为0.1-1g。In another preferred embodiment, the composition is in unit dosage form (one tablet, one capsule or one vial), and the mass of the composition in each unit dosage form is 0.05-5 g, preferably 0.1-1 g.
在另一优选例中,所述的组合物还含有其它益生菌和/或益生元。In another preferred example, the composition further contains other probiotics and/or prebiotics.
在另一优选例中,所述的益生菌选自下组:乳酸菌、双歧杆菌、嗜酸乳杆菌、或其组合。In another preferred embodiment, the probiotics are selected from the group consisting of lactic acid bacteria, bifidobacteria, lactobacillus acidophilus, or a combination thereof.
在另一优选例中,所述的益生元选自下组:低聚果糖(FOS)、低聚半乳糖(GOS)、低聚木糖(XOS)、低聚乳果糖(LACT)、大豆低聚糖(SOS)、菊粉(Inulin)、寡聚糖、或其组合。In another preferred embodiment, the prebiotics are selected from the group consisting of fructooligosaccharides (FOS), galactooligosaccharides (GOS), xylo-oligosaccharides (XOS), lactultooligosaccharides (LACT), soybean low polysaccharides (SOS), inulin (Inulin), oligosaccharides, or combinations thereof.
在另一优选例中,所述组合物还含有有助于保持粪厌氧棒杆菌活力的物质(如保护剂)。In another preferred embodiment, the composition further contains substances (such as protective agents) that help maintain the viability of Corynebacterium faecalis.
在另一优选例中,所述有助于保持粪厌氧棒杆菌活力的物质(如保护剂)选自下组:半胱氨酸、谷胱甘肽、丁基羟基茴香醚、二丁基甲基甲苯、生育酚、竹叶抗氧化物、D-异抗坏血酸及其钠盐、抗坏血酸钠、抗坏血酸钙、磷脂、维生素C(抗坏血酸)、维生素E、或其组合。In another preferred embodiment, the substances (such as protective agents) that help maintain the viability of Corynebacterium faecalis are selected from the group consisting of cysteine, glutathione, butylated hydroxyanisole, dibutylmethyl Toluene, tocopherol, bamboo leaf antioxidants, D-erythorbic acid and its sodium salt, sodium ascorbate, calcium ascorbate, phospholipids, vitamin C (ascorbic acid), vitamin E, or a combination thereof.
在另一优选例中,所述有助于保持粪厌氧棒杆菌活力的物质(如保护剂)的重量比为0.1-2%,较佳地,0.5-1.5%,更佳地,0.5-1%,以所述组合物的总重计。In another preferred embodiment, the weight ratio of the substances (such as protective agents) that help to maintain the viability of Corynebacterium faecalis is 0.1-2%, preferably 0.5-1.5%, more preferably 0.5-2% 1%, based on the total weight of the composition.
在另一优选例中,以组合物1g计,所述有助于保持粪厌氧棒杆菌活力的物质(如保护剂)的含量为1mg-20mg,较佳地,5mg-15mg,更佳地,5mg-10mg。In another preferred example, based on 1 g of the composition, the content of the substance (such as a protective agent) that helps to maintain the viability of Corynebacterium faecalis is 1 mg-20 mg, preferably 5 mg-15 mg, more preferably , 5mg-10mg.
本发明第三方面提供了一种本发明第一方面所述粪厌氧棒杆菌、或本发明第二方面所述组合物的用途,用于制备药物或制剂,所述药物或制剂用于预防和/或治疗炎症相关疾病。The third aspect of the present invention provides the use of the Corynebacterium faecalis described in the first aspect of the present invention, or the composition described in the second aspect of the present invention, for preparing a medicament or a preparation, and the medicament or preparation is used for prevention and/or treatment of inflammation-related diseases.
在另一优选例中,所述炎症相关疾病选自下组:炎症性肠病、类风湿性关节炎、或其组合。In another preferred embodiment, the inflammation-related disease is selected from the group consisting of inflammatory bowel disease, rheumatoid arthritis, or a combination thereof.
在另一优选例中,所述炎症相关疾病选自下组:溃疡性肠炎、胃炎、普通肠炎、或其组合。In another preferred embodiment, the inflammation-related disease is selected from the group consisting of ulcerative colitis, gastritis, common colitis, or a combination thereof.
在另一优选例中,所述制剂包括微生态制剂。In another preferred embodiment, the preparation includes a probiotic preparation.
本发明第四方面提供了一种本发明第一方面所述粪厌氧棒杆菌、或本发明第二方面所述组合物的用途,用于制备药物或制剂,所述药物或制剂用于选自下组的一种或多种用途:The fourth aspect of the present invention provides the use of the Corynebacterium faecalis described in the first aspect of the present invention, or the composition described in the second aspect of the present invention, for preparing a medicament or a preparation, and the medicament or preparation is used for selecting One or more uses from the following group:
(i)减缓哺乳动物体重的下降;(i) slowing down the weight loss of mammals;
(ii)降低哺乳动物的疾病活动指数(DAI);(ii) reducing the disease activity index (DAI) in mammals;
(iii)改善哺乳动物肠道病变。(iii) Improve mammalian intestinal lesions.
在另一优选例中,所述哺乳动物包括人、啮齿动物(如大鼠、小鼠)。In another preferred embodiment, the mammals include humans and rodents (eg, rats, mice).
在另一优选例中,所述减缓哺乳动物体重的下降指与模型组哺乳动物相比,实验组哺乳动物体重的降低幅度为不超过15%,较佳地,不超过10%,更佳地,不超过5%,显著低于模型组哺乳动物体重的降低幅度。In another preferred embodiment, the slowing down of the weight loss of mammals refers to that compared with the mammals in the model group, the reduction in the body weight of the mammals in the experimental group is no more than 15%, preferably no more than 10%, more preferably , not more than 5%, significantly lower than the reduction in body weight of mammals in the model group.
在另一优选例中,所述减缓哺乳动物肠道的病变包括减缓结肠长度的缩短、和/或减轻结肠炎症反应。In another preferred embodiment, the slowing down of the pathological changes of the mammalian intestine includes slowing down the length of the colon and/or alleviating the inflammatory response of the colon.
本发明第五方面提供了一种本发明第二方面所述组合物的制法,包括步骤:The fifth aspect of the present invention provides a preparation method of the composition described in the second aspect of the present invention, comprising the steps:
将本发明第一方面所述的粪厌氧棒杆菌和/或其代谢产物与食品上可接受的载体或药学上可接受的载体混合,从而形成本发明第二方面所述的组合物。The Corynebacterium faecalis and/or its metabolites described in the first aspect of the present invention are mixed with a food acceptable carrier or a pharmaceutically acceptable carrier to form the composition described in the second aspect of the present invention.
在另一优选例中,所述制法还包括与生长因子混合的步骤。In another preferred embodiment, the preparation method further includes the step of mixing with growth factors.
在另一优选例中,所述制法还包括与有助于保持粪厌氧棒杆菌活力的物质(如保护剂)混合的步骤。In another preferred embodiment, the preparation method further includes the step of mixing with a substance (such as a protective agent) that helps maintain the viability of Corynebacterium faecalis.
在另一优选例中,所述有助于保持粪厌氧棒杆菌活力的物质(如保护剂)选自下组:半胱氨酸、谷胱甘肽、丁基羟基茴香醚、二丁基甲基甲苯、生育酚、竹叶抗氧化物、D-异抗坏血酸及其钠盐、抗坏血酸钠、抗坏血酸钙、磷脂、维生素C(抗坏血酸)、维生素E、或其组合。In another preferred embodiment, the substances (such as protective agents) that help maintain the viability of Corynebacterium faecalis are selected from the group consisting of cysteine, glutathione, butylated hydroxyanisole, dibutylmethyl Toluene, tocopherol, bamboo leaf antioxidants, D-erythorbic acid and its sodium salt, sodium ascorbate, calcium ascorbate, phospholipids, vitamin C (ascorbic acid), vitamin E, or a combination thereof.
在另一优选例中,所述制法还包括与益生菌、和/或益生元混合的步骤。In another preferred example, the preparation method further includes the step of mixing with probiotics and/or prebiotics.
在另一优选例中,所述的益生菌选自下组:乳酸菌、双歧杆菌、嗜酸乳杆菌、或其组合。In another preferred embodiment, the probiotics are selected from the group consisting of lactic acid bacteria, bifidobacteria, lactobacillus acidophilus, or a combination thereof.
在另一优选例中,所述的益生元选自下组:低聚果糖(FOS)、低聚半乳糖(GOS)、低聚木糖(XOS)、低聚乳果糖(LACT)、大豆低聚糖(SOS)、菊粉(Inulin)、寡聚糖、或其组合。In another preferred embodiment, the prebiotics are selected from the group consisting of fructooligosaccharides (FOS), galactooligosaccharides (GOS), xylo-oligosaccharides (XOS), lactultooligosaccharides (LACT), soybean low polysaccharides (SOS), inulin (Inulin), oligosaccharides, or combinations thereof.
在另一优选例中,所述生长因子为牛奶生长因子。In another preferred example, the growth factor is a milk growth factor.
在另一优选例中,所述生长因子选自下组:维生素类物质、嘌呤类物质、嘧啶类物质、或其组合。In another preferred embodiment, the growth factor is selected from the group consisting of vitamins, purines, pyrimidines, or a combination thereof.
在另一优选例中,所述组合物为口服制剂。In another preferred embodiment, the composition is an oral preparation.
本发明第六方面提供了一种生产方法,包括步骤:A sixth aspect of the present invention provides a production method, comprising the steps:
(a)在适合培养的条件下,对本发明第一方面所述的粪厌氧棒杆菌进行培养,从而获得培养产物;(a) under conditions suitable for cultivation, the Corynebacterium faecalis described in the first aspect of the present invention is cultivated, thereby obtaining a culture product;
(b)任选地,从所述培养产物分离粪厌氧棒杆菌菌体和/或其代谢产物;和/或(b) optionally, isolating Corynebacterium faecalis cells and/or their metabolites from the culture product; and/or
(c)任选地,将上一步骤获得的培养产物或粪厌氧棒杆菌菌体和/或其代谢产物与食品上可接受的载体或药学上可接受的载体混合,从而制得本发明所述的组合物。(c) optionally, mixing the cultured product obtained in the previous step or Corynebacterium faecalis thalline and/or its metabolite with a food acceptable carrier or a pharmaceutically acceptable carrier to obtain the present invention the described composition.
在另一优选例中,在步骤(c)之前,还包括将上一步骤获得的所述培养产物或所述粪厌氧棒杆菌菌体和/或其代谢产物与生长因子混合的步骤。In another preferred embodiment, before step (c), it also includes the step of mixing the cultured product obtained in the previous step or the Corynebacterium faecalis cells and/or their metabolites with growth factors.
在另一优选例中,所述生长因子为牛奶生长因子。In another preferred example, the growth factor is a milk growth factor.
在另一优选例中,所述生长因子选自下组:维生素类物质、嘌呤类物质、嘧啶类物质、或其组合。In another preferred embodiment, the growth factor is selected from the group consisting of vitamins, purines, pyrimidines, or a combination thereof.
在另一优选例中,在步骤(c)之前,还包括将上一步骤获得的所述培养产物或所述粪厌氧棒杆菌菌体和/或其代谢产物与有助于保持粪厌氧棒杆菌活力的物质(如保护剂)混合的步骤。In another preferred embodiment, before step (c), it also includes combining the cultured product obtained in the previous step or the faecal anaerobic Corynebacterium bacterium and/or its metabolites with help to maintain fecal anaerobic The step of mixing coryneform bacteria viability substances (such as protective agents).
在另一优选例中,在步骤(c)之前,还包括将上一步骤获得的所述培养产物或所述粪厌氧棒杆菌菌体和/或其代谢产物与益生菌和/或益生元混合的步骤。In another preferred example, before step (c), it also includes combining the cultured product obtained in the previous step or the bacterium of Corynebacterium faecalis and/or its metabolites with probiotics and/or prebiotics mixing steps.
本发明第七方面提供了一种改善哺乳动物肠道病变的方法,给所述对象施用本发明第二方面所述的组合物。The seventh aspect of the present invention provides a method for improving intestinal lesions in mammals, by administering the composition of the second aspect of the present invention to the subject.
在另一优选例中,所述的施用包括口服。In another preferred embodiment, the administration comprises oral administration.
在另一优选例中,所述的施用剂量为0.01-5g/50kg体重/天,较佳地,0.1-2g/50kg体重/天。In another preferred embodiment, the administration dose is 0.01-5g/50kg body weight/day, preferably 0.1-2g/50kg body weight/day.
在另一优选例中,所述的对象包括哺乳动物,如人。In another preferred embodiment, the subject includes mammals, such as humans.
本发明第八方面提供了一种减缓哺乳动物体重的下降、和/或降低哺乳动物的疾病活动指数(DAI)的方法,给所述对象施用本发明第二方面所述的组合物。An eighth aspect of the present invention provides a method of slowing down weight loss in a mammal, and/or reducing a disease activity index (DAI) in a mammal, by administering the composition of the second aspect of the present invention to the subject.
在另一优选例中,所述的施用包括口服。In another preferred embodiment, the administration comprises oral administration.
在另一优选例中,所述的施用剂量为0.01-5g/50kg体重/天,较佳地,0.1-2g/50kg体重/天。In another preferred embodiment, the administration dose is 0.01-5g/50kg body weight/day, preferably 0.1-2g/50kg body weight/day.
在另一优选例中,所述的对象包括哺乳动物,如人。In another preferred embodiment, the subject includes mammals, such as humans.
应理解,在本发明范围内中,本发明的上述各技术特征和在下文(如实施例)中具体描述的各技术特征之间都可以互相组合,从而构成新的或优选的技术方案。限于篇幅,在此不再一一累述。It should be understood that within the scope of the present invention, the above-mentioned technical features of the present invention and the technical features specifically described in the following (eg, the embodiments) can be combined with each other to form new or preferred technical solutions. Due to space limitations, it is not repeated here.
附图说明Description of drawings
图1显示了粪厌氧棒杆菌Anaerostipes caccae AF04-45培养48h菌落的图片。Figure 1 shows a picture of the 48h colony of Corynebacterium faecalis Anaerostipes caccae AF04-45 cultured for 48 hours.
图2显示了粪厌氧棒杆菌Anaerostipes caccae AF04-45在显微镜下的革兰氏染色图片(1000倍)。Figure 2 shows a Gram-stained picture of Corynebacterium faecalis Anaerostipes caccae AF04-45 under a microscope (1000x).
图3显示了Control组、模型组、VSL#3和AF04-45治疗组小鼠的体重的变化。Figure 3 shows the changes in body weight of mice in Control group, model group,
图4显示了Control组、模型组、VSL#3和AF04-45治疗组小鼠的DAI指数的变化。Figure 4 shows the changes in DAI index of mice in Control group, model group,
图5显示了Control组、模型组、VSL#3和AF04-45治疗组小鼠结肠的长度。Figure 5 shows the length of the colons of mice in the Control, Model,
具体实施方式Detailed ways
本发明人经过广泛而深入的研究和实验,意外地发现,粪厌氧棒杆菌(Anaerostipes caccae)具有预防和/或治疗炎症相关疾病(如炎症性肠病(如溃疡性肠炎、胃炎、普通肠炎)、类风湿性关节炎)的作用,将含有粪厌氧棒杆菌的活性组合物饲喂食实验对象,发现该组合物能够减缓体重降低,降低疾病活动指数(DAI),改善肠道病变,可有效减轻炎症相关疾病(如炎症性肠病(如溃疡性肠炎、胃炎、普通肠炎)、类风湿性关节炎))等病症。在此基础上完成本发明。After extensive and in-depth research and experiments, the present inventors unexpectedly found that Corynebacterium faecalis (Anaerostipes caccae) has the ability to prevent and/or treat inflammation-related diseases (such as inflammatory bowel diseases (such as ulcerative colitis, gastritis, common enteritis) ), rheumatoid arthritis), the active composition containing Corynebacterium faecalis was fed to experimental subjects, and it was found that the composition could slow down weight loss, reduce disease activity index (DAI), improve intestinal lesions, and can Effectively reduce inflammation-related diseases (such as inflammatory bowel disease (such as ulcerative colitis, gastritis, common enteritis), rheumatoid arthritis) and other conditions. The present invention has been completed on this basis.
如本文所用,术语“含有”表示各种成分可一起应用于本发明的混合物或组合物中。因此,术语“主要由...组成”和“由...组成”包含在术语“含有”中。As used herein, the term "comprising" means that the various ingredients can be used together in the mixture or composition of the present invention. Thus, the terms "consisting essentially of" and "consisting of" are encompassed by the term "comprising".
如本文所用,术语“生长因子”包括牛奶生长因子,具体地,包括维生素类物质、嘌呤类物质、嘧啶类物质、或其组合的营养物质。As used herein, the term "growth factor" includes milk growth factors, specifically, nutrients including vitamins, purines, pyrimidines, or combinations thereof.
其中,所述维生素类物质包括(但并不限于):维生素C、维生素E、维生素A、维生素A前体、维生素B6、维生素D3、维生素K、叶酸、或其组合;Wherein, the vitamin substances include (but are not limited to): vitamin C, vitamin E, vitamin A, vitamin A precursor, vitamin B6 , vitamin D3 , vitamin K, folic acid, or a combination thereof;
所述嘌呤类物质包括(但并不限于):嘌呤核苷,其中所述嘌呤核苷包括嘌呤核苷的5’-磷酸酯;所述嘌呤核苷的5’-磷酸酯选自下组:肌苷酸(肌苷-5’-磷酸酯;IMP)、鸟苷酸(鸟苷-5’-磷酸酯;GMP)、黄苷酸(黄嘌呤核苷-5’-磷酸酯;XMP)、腺苷酸(腺苷-5’-磷酸酯;AMP)、或其组合;The purine substances include (but are not limited to): purine nucleosides, wherein the purine nucleosides include 5'-phosphate esters of purine nucleosides; the 5'-phosphate esters of purine nucleosides are selected from the group consisting of: Inosinic acid (inosine-5'-phosphate; IMP), guanylic acid (guanosine-5'-phosphate; GMP), xanthine (xanthine-5'-phosphate; XMP), adenylate (adenosine-5'-phosphate; AMP), or a combination thereof;
所述嘧啶类物质包括所有含嘧啶结构的物质。The pyrimidines include all pyrimidine-containing substances.
如本文所用,术语“控制哺乳动物体重下降”、“减缓哺乳动物体重下降”可互换使用,是指哺乳动物在进行溃疡性肠炎模型构建过程中由于炎症的不断严重,实验动物的体重也随之下降,体重下降的百分比为下降体重占原始体重的百分比。体重下降的程度越高,疾病越严重,本发明的粪厌氧棒杆菌在对哺乳动物溃疡性肠炎治疗过程中可以控制实验动物的体重下降,减缓疾病的症状。As used herein, the terms "controlling the weight loss of mammals" and "slowing down the weight loss of mammals" are used interchangeably, and refer to the fact that the body weight of the experimental animals changes with the increase of inflammation during the establishment of the ulcerative colitis model in mammals. The percentage of weight loss is the percentage of the original body weight. The higher the degree of body weight loss, the more serious the disease, and the Corynebacterium faecalis of the present invention can control the body weight loss of experimental animals and alleviate the symptoms of the disease during the treatment of mammalian ulcerative colitis.
疾病活动指数(DAI)Disease Activity Index (DAI)
如本文所用,术语“疾病活动指数”是指结合患者(患病动物)的体重下降百分率、大便粘稠度和大便出血情况3种情况进行综合评分。As used herein, the term "disease activity index" refers to a comprehensive score that combines the percentage of weight loss, stool consistency and stool bleeding in patients (affected animals).
粪厌氧棒杆菌及其应用Corynebacterium faecalis and its application
如本文所用,术语“粪厌氧棒杆菌”、“Anaerostipes caccae”、“本发明的粪厌氧棒杆菌”可互换使用。在一个优选例中,所述菌株为Anaerostipes caccae AF04-45,保藏号为GDMCC No.:60088,分离自人(较佳地,健康女性)的粪便中,具体地,分离自成年女性的肠道中。粪厌氧棒杆菌的生理特性如下:粪厌氧棒杆菌(Anaerostipes caccae AF04-45)37℃厌氧培养2天的菌落为淡黄色,凸起,较粘稠,不透明,近圆形,边缘整齐,直径约2-3mm;显微镜下放大1000倍粪厌氧棒杆菌(Anaerostipes caccae AF04-45)的菌体为杆状,革兰氏阴性,不产芽孢和鞭毛。粪厌氧棒杆菌(Anaerostipes caccae AF04-45)为过氧化氢酶阴性,氧化酶阴性,严格厌氧,在0.3%的胆盐中4h的存活率高达100%。能发酵多种碳水化合物,包括葡萄糖、甘露糖、蔗糖、麦芽糖、木糖、甘露醇、山梨醇等,主要产生乳酸、丁二酸、戊酸、3-甲基丁酸、柠檬酸等,并且本发明的粪厌氧棒杆菌(Anaerostipes caccae AF04-45)对表4所示的20种抗生素均比较敏感。As used herein, the terms "Corynebacterium faecalis", "Anaerostipes caccae", "Corynebacterium faecalis of the present invention" are used interchangeably. In a preferred example, the strain is Anaerostipes caccae AF04-45, the deposit number is GDMCC No.: 60088, which is isolated from the feces of humans (preferably, healthy women), specifically, isolated from the intestines of adult women Road. The physiological characteristics of Corynebacterium faecalis are as follows: Corynebacterium faecalis (Anaerostipes caccae AF04-45) anaerobic culture at 37°C for 2 days is pale yellow, raised, viscous, opaque, nearly round, with neat edges , about 2-3mm in diameter; under the microscope, the bacterium of Anaerostipes caccae AF04-45 is rod-shaped, gram-negative, and does not produce spores and flagella. Corynebacterium faecalis (Anaerostipes caccae AF04-45) is catalase-negative, oxidase-negative, strictly anaerobic, and has a survival rate of 100% for 4 hours in 0.3% bile salts. Can ferment a variety of carbohydrates, including glucose, mannose, sucrose, maltose, xylose, mannitol, sorbitol, etc., mainly producing lactic acid, succinic acid, valeric acid, 3-methylbutyric acid, citric acid, etc., and Corynebacterium faecalis (Anaerostipes caccae AF04-45) of the present invention is relatively sensitive to the 20 antibiotics shown in Table 4.
本发明提供了粪厌氧棒杆菌在治疗和/或预防炎症相关疾病(如炎症性肠病(如溃疡性肠炎、胃炎、普通肠炎)、类风湿性关节炎)的应用。受试者用DSS(葡聚糖硫酸钠)进行诱导造模,菌株Anaerostipes caccae AF04-45具有选自下组的一个或多个用途:(i)减缓该受试者的体重降低;(ii)改善肠道病变程度;(iii)降低疾病活动指数(DAI)。根据本发明的一个优选例,采用C57b1/6小鼠作为试验小鼠,用DSS(葡聚糖硫酸钠)进行诱导造模,从而获得溃疡性肠炎(UC)模型小鼠,经Anaerostipes caccae AF04-45来治疗的UC模型小鼠,与未接受治疗的对照组(模型组)相比,其体重降低幅度减缓,并且各种与炎症相关疾病(如炎症性肠病)相关的指标也得到改善,如改善肠道病变程度(包括减缓结肠长度的缩短、和/或减轻结肠炎症反应)、降低疾病活动指数(DAI)等。因此,所述菌株能够用以预防和/或治疗炎症相关疾病(如炎症性肠病(如溃疡性肠炎、胃炎、普通肠炎)、类风湿性关节炎)。The present invention provides the application of Corynebacterium faecalis in treating and/or preventing inflammation-related diseases (eg, inflammatory bowel disease (eg, ulcerative colitis, gastritis, common enteritis), rheumatoid arthritis). The subject was modelled with DSS (dextran sodium sulfate), the strain Anaerostipes caccae AF04-45 having one or more uses selected from the group consisting of: (i) slowing the subject's weight loss; (ii) Improve the degree of intestinal lesions; (iii) reduce the disease activity index (DAI). According to a preferred example of the present invention, C57b1/6 mice were used as test mice, and DSS (dextran sodium sulfate) was used to induce modeling to obtain ulcerative colitis (UC) model mice. Anaerostipes caccae AF04- Compared with the untreated control group (model group), the UC model mice treated with 45 to 45 years had a slower rate of weight loss, and various indicators related to inflammation-related diseases (such as inflammatory bowel disease) were also improved, Such as improving the degree of intestinal lesions (including slowing the shortening of colon length, and/or reducing colonic inflammation), reducing disease activity index (DAI), etc. Therefore, the strain can be used to prevent and/or treat inflammation-related diseases (eg, inflammatory bowel disease (eg, ulcerative colitis, gastritis, common enteritis), rheumatoid arthritis).
组合物及其应用Composition and its application
本发明还提供了一种组合物,较佳地,所述组合物包括食品组合物、保健组合物、药物组合物、饮料组合物、或饲料组合物,优选地,为药物组合物。所述组合物包括有效量的粪厌氧棒杆菌,在一个优选例中,所述组合物还包括生长因子(如牛奶生长因子)。在一个优选例中,所述组合物还包括选自下组的益生菌:乳酸菌、双歧杆菌、嗜酸乳杆菌、或其组合;和/或选自下组的益生元:低聚果糖(FOS)、低聚半乳糖(GOS)、低聚木糖(XOS)、低聚乳果糖(LACT)、大豆低聚糖(SOS)、菊粉(Inulin)、寡聚糖、或其组合。在一个优选例中,所述组合物还包括选自下组的有助于保持粪厌氧棒杆菌活力的物质(如保护剂):半胱氨酸、谷胱甘肽、丁基羟基茴香醚、二丁基甲基甲苯、生育酚、竹叶抗氧化物、D-异抗坏血酸及其钠盐、抗坏血酸钠、抗坏血酸钙、磷脂、维生素C(抗坏血酸)、维生素E、或其组合。以组合物的总重计,所述有助于保持粪厌氧棒杆菌活力的物质(如保护剂)的重量比为0.1-2%,较佳地,0.5-1.5%,更佳地,0.5-1%。The present invention also provides a composition, preferably, the composition includes a food composition, a health care composition, a pharmaceutical composition, a beverage composition, or a feed composition, preferably a pharmaceutical composition. The composition includes an effective amount of Corynebacterium faecalis, and in a preferred embodiment, the composition further includes a growth factor (eg, milk growth factor). In a preferred example, the composition further comprises probiotics selected from the group consisting of lactic acid bacteria, bifidobacteria, lactobacillus acidophilus, or a combination thereof; and/or prebiotics selected from the group consisting of fructooligosaccharides ( FOS), galactooligosaccharides (GOS), xylo-oligosaccharides (XOS), lactultooligosaccharides (LACT), soybean oligosaccharides (SOS), inulin (Inulin), oligosaccharides, or combinations thereof. In a preferred embodiment, the composition further comprises substances (such as protective agents) that are selected from the group consisting of cysteine, glutathione, butylated hydroxyanisole that help maintain the viability of Corynebacterium faecalis , dibutyl methyl toluene, tocopherol, bamboo leaf antioxidants, D-isoascorbic acid and its sodium salt, sodium ascorbate, calcium ascorbate, phospholipids, vitamin C (ascorbic acid), vitamin E, or a combination thereof. Based on the total weight of the composition, the weight ratio of the substances that help to maintain the viability of Corynebacterium faecalis (such as protective agents) is 0.1-2%, preferably 0.5-1.5%, more preferably 0.5% -1%.
在一优选例中,所述的组合物为液态制剂、固态制剂、半固态制剂。In a preferred example, the composition is a liquid preparation, a solid preparation, or a semi-solid preparation.
在一优选例中,所述的液态制剂选自下组:溶液制品或悬浮液制品。In a preferred embodiment, the liquid preparation is selected from the following group: a solution product or a suspension product.
在一优选例中,所述的组合物的剂型选自下组:粉末剂、散剂、片剂、糖衣剂、胶囊剂、颗粒剂、悬浮剂、溶液剂、糖浆剂、滴剂、舌下含片、或其组合。In a preferred embodiment, the dosage form of the composition is selected from the following group: powder, powder, tablet, sugar coating, capsule, granule, suspension, solution, syrup, drop, sublingual tablet, or a combination thereof.
本发明的组合物可以以口服液、片剂、针剂、口崩片、冻干粉制剂或胶囊的任一种形式给药,优选肠溶剂型(如胶囊),在本发明中,如无特别说明,本发明所用的赋形剂、药物允许的媒介和载体主要是根据适合菌或其代谢产物特性和所需的特定给药方式进行选择,有利于菌或其代谢产物顺利通过胃而被给药者吸收。这些物质可根据给药途径进行选择。The composition of the present invention can be administered in any form of oral liquid, tablet, injection, orally disintegrating tablet, lyophilized powder preparation or capsule, preferably enteric form (such as capsule), in the present invention, if no special It is indicated that the excipients, pharmaceutically acceptable media and carriers used in the present invention are mainly selected according to the characteristics of suitable bacteria or their metabolites and the specific administration mode required, which is conducive to the smooth passage of bacteria or their metabolites through the stomach. Medications are absorbed. These substances can be selected according to the route of administration.
本发明的组合物可进一步包含那些通常用于药物制剂的赋形剂中任何附加的赋形剂,为的是例如稳定组合物自身,或使其容易地分散或赋予其适宜的味道。The compositions of the present invention may further comprise any additional excipients among those commonly used in pharmaceutical formulations, for example to stabilize the composition itself, or to disperse it easily or to impart a suitable taste.
在所述赋形剂当中,菊粉、果糖、淀粉、低聚木糖、二氧化硅、缓冲试剂以及风味剂是合适的实例。Among such excipients, inulin, fructose, starch, xylo-oligosaccharides, silicon dioxide, buffering agents and flavoring agents are suitable examples.
本发明中药物制剂可进一步包含辅助的活性组份。The pharmaceutical formulations of the present invention may further comprise auxiliary active ingredients.
乳糖、麦芽糊精、葡萄糖、蔗糖、山梨糖醇、甘露糖、淀粉、阿拉伯胶、磷酸钙、藻酸盐、明胶、硅酸钙、细结晶纤维素、聚乙烯吡咯烷酮(PVP)、纤维素、水、糖浆、甲基纤维素、羟基苯甲酸甲酯、羟基苯甲酸丙酯、滑石、硬脂酸镁或矿物油等都可用作本发明中药物组合物的载体、赋形剂或稀释剂等。Lactose, maltodextrin, glucose, sucrose, sorbitol, mannose, starch, gum arabic, calcium phosphate, alginate, gelatin, calcium silicate, fine crystalline cellulose, polyvinylpyrrolidone (PVP), cellulose, Water, syrup, methyl cellulose, methyl hydroxybenzoate, propyl hydroxybenzoate, talc, magnesium stearate or mineral oil etc. can be used as the carrier, excipient or diluent of the pharmaceutical composition of the present invention Wait.
此外,本发明的药物组合物可进一步包括润滑剂、润湿剂、乳化剂、悬浮液稳定剂、防腐剂、甜味剂和香料等。本发明的药物组合物可通过多种公知的方法以肠衣制剂生产,以便于药物组合物的活性成分即微生物能顺利通过胃而不被胃酸所破坏。In addition, the pharmaceutical composition of the present invention may further include lubricants, wetting agents, emulsifiers, suspension stabilizers, preservatives, sweeteners, flavors, and the like. The pharmaceutical composition of the present invention can be produced in enteric-coated formulations by various well-known methods so that the active ingredient of the pharmaceutical composition, ie, microorganisms, can pass smoothly through the stomach without being destroyed by gastric acid.
另外,本发明的微生物可以常规方法制备的胶囊形式使用。例如,标准赋形剂和本发明的冷干微生物混合制成小球药丸,然后将药丸装填入明胶胶囊中。此外,本发明的微生物和药物允许使用的赋形剂如液体胶、纤维素、硅酸盐或矿物油等混合制作悬浮液或分散液,这种悬浮液或分散液可装入软的明胶胶囊中。In addition, the microorganisms of the present invention can be used in the form of capsules prepared by conventional methods. For example, standard excipients and the freeze-dried microorganisms of the present invention are mixed to form pellets, which are then filled into gelatin capsules. In addition, the microorganisms and medicaments of the present invention allow the use of excipients such as liquid gum, cellulose, silicate or mineral oil, etc., to be mixed to make suspensions or dispersions, which can be filled into soft gelatin capsules middle.
本发明的药物组合物可制成肠衣片供口服使用。本申请中的术语-“肠衣”,包括所有常规药物允许使用的包衣,这些包衣不被胃酸降解,但在小肠中能充分分解并快速释放出本发明的微生物。本发明的肠衣能在合成胃酸如pH=1的HCl溶液中在36-38℃维持2小时以上,并优选在合成肠液如pH=7.0的缓冲液中在1.0小时内分解。The pharmaceutical composition of the present invention can be made into enteric-coated tablets for oral use. The term - "enteric coating" in this application includes all conventional pharmaceutical acceptable coatings which are not degraded by gastric acid, but which break down sufficiently in the small intestine to rapidly release the microorganisms of the invention. The enteric coating of the present invention can be maintained in synthetic gastric acid such as pH=1 HCl solution at 36-38°C for more than 2 hours, and preferably decomposes within 1.0 hour in synthetic intestinal fluid such as pH=7.0 buffer.
本发明的肠衣为以每片约16-30mg进行包衣,较佳地16-25mg,更佳地16-20mg进行包衣。本发明中肠衣厚度为5-100μm,理想的厚度为20-80μm。肠衣成分选自己公开知晓的常规聚合物。The enteric coating of the present invention is coated at about 16-30 mg per tablet, preferably 16-25 mg, more preferably 16-20 mg. In the present invention, the thickness of the casing is 5-100 μm, and the ideal thickness is 20-80 μm. The enteric coating ingredients are selected from conventional polymers known to the public.
本发明优选的肠衣由纤维素乙酸邻苯二甲酸酯聚合物或偏苯三酸酯聚合物以及异丁烯酸的共聚物(例如,含有40%以上异丁烯酸和含有甲基纤维素邻苯二甲酸羟丙酯或其酯类衍生物的异丁烯酸的共聚物)制备。The preferred enteric coating of the present invention is composed of a cellulose acetate phthalate polymer or a trimellitate polymer and a copolymer of methacrylic acid (for example, containing more than 40% methacrylic acid and containing methyl cellulose phthalic acid) Copolymers of methacrylic acid of hydroxypropyl ester or its ester derivatives).
本发明中肠衣所使用的纤维素乙酸邻苯二甲酸酯的粘度为约45-90cp,乙酰含量17-26%,邻苯二甲酸含量30-40%。用于肠衣中的纤维素乙酸偏苯三酸酯粘度为约5-21cs,乙酞含量17-26%。纤维素乙酸偏苯三酸酯由Eastman科达公司生产,可用于本发明中的肠衣材料。The viscosity of the cellulose acetate phthalate used in the enteric coating of the present invention is about 45-90 cp, the acetyl content is 17-26%, and the phthalic acid content is 30-40%. Cellulose acetate trimellitate used in enteric coatings has a viscosity of about 5-21 cs and an acetphthalide content of 17-26%. Cellulose acetate trimellitate is produced by Eastman Keda Company and can be used for the casing material in the present invention.
用于本发明肠衣中的羟丙基甲基纤维素邻苯二甲酸酯,分子量一般为20,000-130,000道尔顿,理想分子量为80,000-100,000道尔顿,羟丙基含量为5-10%,甲氧基含量为18-24%,邻苯二甲酰基含量为21-35%。The hydroxypropyl methylcellulose phthalate used in the casing of the present invention has a molecular weight of generally 20,000-130,000 daltons, an ideal molecular weight of 80,000-100,000 daltons, and a hydroxypropyl content of 5-10% , the content of methoxy group is 18-24%, and the content of phthaloyl group is 21-35%.
用于本发明肠衣中的羟丙基甲基纤维素邻苯二甲酸酯为HP50,由日本Shin-EtsuChemidnl Co.Ltd.生产。HP50含有6-10%羟丙基,20-24%甲氧基,21-27%的丙基,其分子量为84,000道尔顿。另一种肠衣物质为HP55,HP55含有5-9%的羟丙基甲基纤维素邻苯二甲酸酯,18-22%甲氧基,27-35%的邻苯二甲酸,其分子量为78,000道尔顿。The hydroxypropyl methylcellulose phthalate used in the casing of the present invention is HP50, produced by Shin-EtsuChemidnl Co. Ltd., Japan. HP50 contains 6-10% hydroxypropyl, 20-24% methoxy, 21-27% propyl, and has a molecular weight of 84,000 Daltons. Another enteric coating material is HP55, HP55 contains 5-9% hydroxypropyl methylcellulose phthalate, 18-22% methoxy, 27-35% phthalic acid, and has a molecular weight of 78,000 Daltons.
本发明肠衣如下制备:使用常规方法将肠衣溶液喷雾到核心上。该肠包衣方法中所有溶剂为醇类(如乙醇)、酮类(如丙酮)、卤代烃化合物(如二氯甲烷)、或其组合物。将软化剂如二-正丁基邻苯二甲酸酯和三乙酸甘油酯加入到肠衣溶液中,其比例为1份包衣物对约0.05份或约0.3份软化剂。喷雾方法优选连续执行,所喷雾的料量可根据包衣所采用的条件进行控制。喷雾压力可随意调节,一般而言,能在平均1-1.5巴压力下获得理想的结果。The casings of the present invention are prepared by spraying the casing solution onto the core using conventional methods. All solvents in this enteric coating method are alcohols (eg, ethanol), ketones (eg, acetone), halogenated hydrocarbon compounds (eg, methylene chloride), or combinations thereof. Softeners such as di-n-butylphthalate and triacetin are added to the enteric coating solution in a ratio of 1 part coating to about 0.05 or about 0.3 parts softener. The spraying method is preferably carried out continuously, and the amount of material sprayed can be controlled according to the conditions used for coating. The spray pressure can be adjusted at will, in general, ideal results are obtained at an average pressure of 1-1.5 bar.
说明书中“药物有效量”是指可对人和/或动物产生功能或活性的且可被人和/或动物所接受的量。比如,在本发明中,可制备含有1×10-1×1015cfu/ml或cfu/g(特别的,可含有1×104-1×1010cfu/ml或cfu/g;更特别地,可含有1×106-1×1010cfu/ml或cfu/g)的粪厌氧棒杆菌和/或其代谢产物的制剂。"Pharmaceutically effective amount" in the specification refers to an amount that can produce function or activity on humans and/or animals and can be accepted by humans/or animals. For example, in the present invention, it can be prepared to contain 1×10-1×1015 cfu/ml or cfu/g (specially, it can contain 1×104 -1×1010 cfu/ml or cfu/g; more particularly Alternatively, a preparation containing 1×106 to 1×1010 cfu/ml or cfu/g) of Corynebacterium faecalis and/or its metabolites.
当用于制备药物组合物时,所用的粪厌氧棒杆菌或其代谢产物的有效剂量可随施用的模式和待治疗的疾病的严重程度而变化。适用于内服的剂量形式,包含与固态或液态药学上可接受的载体密切混合的约1×10-1×1015cfu/ml或cfu/g(特别的,可含有1×104-1×1010cfu/ml或cfu/g;更特别地,可含有1×106-1×1010cfu/ml或cfu/g)的活性粪厌氧棒杆菌或发酵产生的活性成分。可调节此剂量方案以提供最佳治疗应答。例如,由治疗状况的迫切要求,可每天给予若干次分开的剂量,或将剂量按比例地减少。When used in the preparation of pharmaceutical compositions, the effective dose of C. faecalis or its metabolites employed may vary with the mode of administration and the severity of the disease to be treated. A dosage form suitable for oral administration, comprising about 1×10-1×1015 cfu/ml or cfu/g (specially, may contain 1×104 -1× 1010 cfu/ml or cfu/g; more particularly, may contain 1×106 to 1×1010 cfu/ml or cfu/g) of active Corynebacterium faecalis or an active ingredient produced by fermentation. This dosage regimen can be adjusted to provide optimal therapeutic response. For example, several divided doses may be administered daily, or the dose may be proportionally reduced, as dictated by the exigencies of the therapeutic situation.
所述的粪厌氧棒杆菌或其代谢产物可通过口服等途径给予。固态载体包括:淀粉、乳糖、磷酸二钙、微晶纤维素、蔗糖和白陶土,而液态载体包括:培养基、聚乙二醇、非离子型表面活性剂和食用油(如玉米油、花生油和芝麻油),只要适合粪厌氧棒杆菌或其代谢产物特性和所需的特定给药方式。在制备药物组合物中通常使用的佐剂也可有利地被包括,例如调味剂、色素、防腐剂和抗氧化剂如维生素E、维生素C、BHT和BHA。The described Corynebacterium faecalis or its metabolites can be administered orally or the like. Solid carriers include: starch, lactose, dicalcium phosphate, microcrystalline cellulose, sucrose, and kaolin, while liquid carriers include: culture medium, polyethylene glycols, nonionic surfactants, and edible oils (eg, corn oil, peanut oil, etc.) and sesame oil), as long as it suits the characteristics of C. faecalis or its metabolites and the specific mode of administration required. Adjuvants commonly used in the preparation of pharmaceutical compositions may also advantageously be included, such as flavors, colors, preservatives and antioxidants such as vitamin E, vitamin C, BHT and BHA.
从易于制备和给药的立场看,优选的药物组合物是固态组合物,尤其是片剂和固体填充或液体填充的胶囊。口服给药是优选的。From the standpoint of ease of preparation and administration, the preferred pharmaceutical compositions are solid compositions, especially tablets and solid- or liquid-filled capsules. Oral administration is preferred.
将本发明组合物施用给所述个体,每天给药1次或多次。给药剂量单位表示其形式上能分开且适用于人类或其他所有哺乳动物个体的剂量。每一单位含有药物允许的载体和有效治疗量的本发明微生物。给药量随病人的体重和炎症相关疾病(如炎症性肠病(如溃疡性肠炎、胃炎、普通肠炎)、类风湿性关节炎)、心血管疾病(如高血压、高血脂,冠心病)的严重程度、所包括的补充活性组份和所使用的微生物而变化。此外如可能,可分开给药,并且如需要可连续给药。因此,所述给药量不会对本发明造成限制。此外,本发明中的“组合物”不仅意味着药品而且表示可作为功能性食品和健康补充食品。在一个优选例中,所述组合物包括:饮料、食品、药品、动物饲料等。The compositions of the present invention are administered to the individual one or more times per day. Dosage units for administration represent dosages which can be divided in form and suitable for use in humans or all other mammalian subjects. Each unit contains a pharmaceutically acceptable carrier and a therapeutically effective amount of the microorganism of the invention. The dosage varies with the patient's body weight and inflammation-related diseases (such as inflammatory bowel disease (such as ulcerative colitis, gastritis, common enteritis), rheumatoid arthritis), cardiovascular disease (such as hypertension, hyperlipidemia, coronary heart disease) Severity, supplemental active ingredients included, and microorganisms used. In addition, if possible, the administration may be divided, and if necessary, the administration may be consecutive. Therefore, the said doses do not limit the present invention. In addition, the "composition" in the present invention means not only a medicine but also a functional food and a health supplement. In a preferred example, the composition includes: beverage, food, medicine, animal feed and the like.
在本发明的一个优选例中,还提供了一种食品组合物,它含有有效量的粪厌氧棒杆菌和/或其代谢产物,以及余量的食品上可接受的载体,所述的食品组合物的剂型选自固体、乳品、溶液制品、粉末制品、或悬浮液制品。在一优选例中,所述食品组合物还可含有生长因子(如牛奶生长因子)。在一优选例中,所述组合物还包括选自下组的益生菌:乳酸菌、双歧杆菌、嗜酸乳杆菌、或其组合;和/或选自下组的益生元:低聚果糖(FOS)、低聚半乳糖(GOS)、低聚木糖(XOS)、低聚乳果糖(LACT)、大豆低聚糖(SOS)、菊粉(Inulin)、寡聚糖、或其组合。在一个优选例中,所述组合物还包括选自下组的有助于保持粪厌氧棒杆菌活力的物质(如保护剂):半胱氨酸、谷胱甘肽、丁基羟基茴香醚、二丁基甲基甲苯、生育酚、竹叶抗氧化物、D-异抗坏血酸及其钠盐、抗坏血酸钠、抗坏血酸钙、磷脂、维生素C(抗坏血酸)、维生素E、或其组合。In a preferred embodiment of the present invention, a food composition is also provided, which contains an effective amount of Corynebacterium faecalis and/or its metabolites, and the remainder of a food acceptable carrier, the food The dosage form of the composition is selected from solid, dairy, solution, powder, or suspension preparations. In a preferred embodiment, the food composition may further contain growth factors (eg, milk growth factors). In a preferred embodiment, the composition further comprises probiotics selected from the group consisting of lactic acid bacteria, bifidobacteria, lactobacillus acidophilus, or a combination thereof; and/or prebiotics selected from the group consisting of fructooligosaccharides ( FOS), galactooligosaccharides (GOS), xylo-oligosaccharides (XOS), lactultooligosaccharides (LACT), soybean oligosaccharides (SOS), inulin (Inulin), oligosaccharides, or combinations thereof. In a preferred embodiment, the composition further comprises substances (such as protective agents) that are selected from the group consisting of cysteine, glutathione, butylated hydroxyanisole that help maintain the viability of Corynebacterium faecalis , dibutyl methyl toluene, tocopherol, bamboo leaf antioxidants, D-isoascorbic acid and its sodium salt, sodium ascorbate, calcium ascorbate, phospholipids, vitamin C (ascorbic acid), vitamin E, or a combination thereof.
在一优选例中,所述组合物的配方如下:In a preferred example, the formulation of the composition is as follows:
1×10-1×1015cfu/mL的粪厌氧棒杆菌和/或其代谢产物;以及食品上或药学上可接受的载体,和/或赋形剂。1×10-1×1015 cfu/mL of Corynebacterium faecalis and/or its metabolites; and a food or pharmaceutically acceptable carrier, and/or excipient.
在另一优选例中,所述组合物的配方如下:In another preferred embodiment, the formula of the composition is as follows:
1×104-1×1010cfu/mL的粪厌氧棒杆菌和/或其代谢产物;以及食品上或药学上可接受的载体,和/或赋形剂。1×104 -1×1010 cfu/mL of Corynebacterium faecalis and/or its metabolites; and a food or pharmaceutically acceptable carrier, and/or excipient.
微生态制剂probiotics
微生态制剂是一种包含益生菌及代谢产物的生物制剂或者是可以增加益生菌的膳食补充剂,可以通过调节、维持肠道内微生态平衡,达到提高人体健康水平的目的。主要包括益生菌、益生元和合生元。A probiotic is a biological preparation containing probiotics and metabolites or a dietary supplement that can increase probiotics. It can regulate and maintain the microecological balance in the intestinal tract to improve human health. It mainly includes probiotics, prebiotics and synbiotics.
在本发明中,所述微生态制剂包括(a)安全有效量的粪厌氧棒杆菌和/或其代谢产物;以及(b)食品上可接受的载体或药学上可接受的载体。在一优选例中,所述制剂还包括生长因子(如牛奶生长因子,较佳地,包括维生素类物质、嘌呤类物质、和/或嘧啶类物质)。在一个优选例中,所述制剂还包括选自下组的益生菌:乳酸菌、双歧杆菌、嗜酸乳杆菌、或其组合;和/或选自下组的益生元:低聚果糖(FOS)、低聚半乳糖(GOS)、低聚木糖(XOS)、低聚乳果糖(LACT)、大豆低聚糖(SOS)、菊粉(Inulin)、寡聚糖、或其组合。在一个优选例中,所述组合物还包括选自下组的有助于保持粪厌氧棒杆菌活力的物质(如保护剂):半胱氨酸、谷胱甘肽、丁基羟基茴香醚、二丁基甲基甲苯、生育酚、竹叶抗氧化物、D-异抗坏血酸及其钠盐、抗坏血酸钠、抗坏血酸钙、磷脂、维生素C(抗坏血酸)、维生素E、或其组合。In the present invention, the probiotic preparation comprises (a) a safe and effective amount of Corynebacterium faecalis and/or its metabolites; and (b) a food acceptable carrier or a pharmaceutically acceptable carrier. In a preferred embodiment, the preparation further includes growth factors (eg, milk growth factors, preferably, including vitamins, purines, and/or pyrimidines). In a preferred embodiment, the preparation further comprises probiotics selected from the group consisting of lactic acid bacteria, bifidobacteria, lactobacillus acidophilus, or a combination thereof; and/or prebiotics selected from the group consisting of fructooligosaccharides (FOS). ), galactooligosaccharides (GOS), xylo-oligosaccharides (XOS), lactultooligosaccharides (LACT), soybean oligosaccharides (SOS), inulin (Inulin), oligosaccharides, or a combination thereof. In a preferred embodiment, the composition further comprises substances (such as protective agents) that are selected from the group consisting of cysteine, glutathione, butylated hydroxyanisole that help maintain the viability of Corynebacterium faecalis , dibutyl methyl toluene, tocopherol, bamboo leaf antioxidants, D-isoascorbic acid and its sodium salt, sodium ascorbate, calcium ascorbate, phospholipids, vitamin C (ascorbic acid), vitamin E, or a combination thereof.
粪厌氧棒杆菌的生产方法Production method of fecal anaerobic corynebacterium
通常,粪厌氧棒杆菌可以用常规方法制得。Generally, Corynebacterium faecalis can be prepared by conventional methods.
在本发明中,提供了一种能够大规模生产粪厌氧棒杆菌的方法,具体地,包括如下步骤:In the present invention, a kind of method capable of large-scale production of Corynebacterium faecalis is provided, specifically, comprising the steps:
(a)在适合培养的条件下,对本发明所述的粪厌氧棒杆菌进行培养,从而获得培养产物;(a) under conditions suitable for cultivation, the Corynebacterium faecalis of the present invention is cultivated, thereby obtaining a cultured product;
(b)任选地,从所述培养产物分离粪厌氧棒杆菌菌体和/或其代谢产物;和(c)任选地,将上一步骤获得的培养产物或粪厌氧棒杆菌菌体和/或其代谢产物与食品上可接受的载体或药学上可接受的载体混合,从而制得组合物。(b) optionally, separating Corynebacterium faecalis cells and/or their metabolites from the culture product; and (c) optionally, separating the culture product or Corynebacterium faecalis bacterium obtained in the previous step The body and/or its metabolites are mixed with a food acceptable carrier or a pharmaceutically acceptable carrier to prepare the composition.
改善哺乳动物肠道病变的方法Methods for ameliorating intestinal lesions in mammals
在另一优选例中,所述方法包括:摄取本发明的药物组合物、食品组合物、饮料组合物、或其组合。所述实验对象包括哺乳动物,如人。In another preferred example, the method comprises: ingesting the pharmaceutical composition, food composition, beverage composition, or combination thereof of the present invention. Such subjects include mammals, such as humans.
在另一优选例中,所述方法包括:摄取本发明的药物组合物、食品组合物、或动物饲料,或其组合。所述实验对象为动物,较佳地为鼠类,兔类。In another preferred example, the method comprises: ingesting the pharmaceutical composition, food composition, or animal feed of the present invention, or a combination thereof. The experimental object is an animal, preferably a mouse or a rabbit.
减缓哺乳动物体重的下降、和/或降低哺乳动物的疾病活动指数(DAI)的方法Methods of slowing down weight loss in mammals, and/or reducing disease activity index (DAI) in mammals
在另一优选例中,所述方法包括:摄取本发明的药物组合物、食品组合物、饮料组合物、或其组合。所述实验对象包括哺乳动物,如人。In another preferred example, the method comprises: ingesting the pharmaceutical composition, food composition, beverage composition, or combination thereof of the present invention. Such subjects include mammals, such as humans.
在另一优选例中,所述方法包括:摄取本发明的药物组合物、食品组合物、或动物饲料,或其组合。所述实验对象为动物,较佳地为鼠类,兔类。In another preferred example, the method comprises: ingesting the pharmaceutical composition, food composition, or animal feed of the present invention, or a combination thereof. The experimental object is an animal, preferably a mouse or a rabbit.
菌种保藏strain preservation
本发明的菌种粪厌氧棒杆菌Anaerostipes caccae AF04-45(与保藏名称相同)已于2016年10月13日保藏在广东省微生物菌种保藏中心,地址:广州市先烈中路100号大院59号楼5楼,保藏号:GDMCC No.:60088。The strain of the present invention, Anaerostipes caccae AF04-45 (same as the deposit name), has been deposited in the Guangdong Provincial Microbial Culture Collection Center on October 13, 2016, address: No. 59, Yard, No. 100, Middle Xianlie Road, Guangzhou 5th Floor, Building No.: GDMCC No.: 60088.
本发明的主要优点包括:The main advantages of the present invention include:
(a)本发明的粪厌氧棒杆菌能够显著改善与炎症相关疾病(如炎症性肠病)相关的指标(如减缓体重下降、改善肠道病变程度(包括减缓结肠长度的缩短、减轻结肠炎症反应等)、降低疾病活动指数(DAI)等)。(a) Corynebacterium faecalis of the present invention can significantly improve indicators (such as slowing down weight loss, improving the degree of intestinal lesions (including slowing the shortening of colon length, reducing colon inflammation) related to inflammation-related diseases (such as inflammatory bowel disease) response, etc.), reduction of disease activity index (DAI), etc.).
下面结合具体实施例,进一步阐述本发明。应理解,这些实施例仅用于说明本发明而不用于限制本发明的范围。下列实施例中未注明具体条件的实验方法,通常按照常规条件如Sambrook等人,分子克隆:实验室手册(New York:Cold Spring Harbor LaboratoryPress,1989)中所述的条件,或按照《微生物:实验手册》(James Cappuccino和NatalieSherman编,Pearson Education出版社)中所述的条件,或按照制造厂商所建议的条件。The present invention will be further described below in conjunction with specific embodiments. It should be understood that these examples are only used to illustrate the present invention and not to limit the scope of the present invention. The experimental method of unreceipted specific conditions in the following examples, usually according to normal conditions such as people such as Sambrook, molecular cloning: conditions described in laboratory manual (New York: Cold Spring Harbor Laboratory Press, 1989), or according to "microorganism: Conditions described in the Laboratory Manual (edited by James Cappuccino and Natalie Sherman, Pearson Education Press), or as suggested by the manufacturer.
如无特别说明,实施例所用的材料和试剂均为市售产品。Unless otherwise specified, the materials and reagents used in the examples are all commercially available products.
VSL#3,购自美国Sigma-Tau。
Anaerostipes caccae DSMZ 14662,购自德国微生物菌种保藏中心,保藏号为DSMZ 14662。Anaerostipes caccae DSMZ 14662, purchased from the German Collection of Microorganisms, the deposit number is DSMZ 14662.
实施例1:粪厌氧棒杆菌Anaerostipes caccae AF04-45(简称AF04-45)的分离鉴定Example 1: Isolation and identification of fecal anaerobic corynebacterium Anaerostipes caccae AF04-45 (AF04-45 for short)
1.1分离培养1.1 Isolation and culture
分离样品来自于深圳一位健康女性的新鲜粪便样品,分离培养基为厌氧PYG培养基(购自环凯微生物科技公司),培养基成分如表1-1、表1-2:The isolated sample came from a fresh fecal sample of a healthy woman in Shenzhen. The isolated medium was anaerobic PYG medium (purchased from Huankai Microorganism Technology Co., Ltd.), and the medium components were shown in Table 1-1 and Table 1-2:
表1-1 PYG培养基成分Table 1-1 Composition of PYG medium
表1-2无机盐溶液的配方Table 1-2 Formulation of inorganic salt solution
按照以上成分配制好培养基,115℃高压灭菌25min,固体培养基需要转入厌氧箱中进行平板的倾倒,晾干备用。Prepare the medium according to the above ingredients, sterilize it by autoclaving at 115°C for 25 minutes, and transfer the solid medium into an anaerobic box for pouring of the plate and dry it for later use.
新鲜粪便立即转移至厌氧箱中,取约0.2g悬浮于灭菌的PBS(磷酸盐缓冲液)中,充分吹打分散,然后进行梯度稀释涂布,平板放置在厌氧箱中37℃培养3-5天,厌氧气体组成为氮气∶氢气∶二氧化碳=90∶5∶5。待平板长出肉眼可见的菌落,挑取单个菌落进行划线分纯,并对分纯的单菌进行保藏和鉴定。The fresh feces were immediately transferred to the anaerobic box, and about 0.2 g was suspended in sterilized PBS (phosphate buffered saline), fully dispersed by pipetting, and then subjected to gradient dilution coating. -5 days, the anaerobic gas composition was nitrogen:hydrogen:carbon dioxide=90:5:5. When visible colonies are grown on the plate, a single colony is picked for streaking and purification, and the purified single bacteria are preserved and identified.
1.2 16S rDNA鉴定1.2 16S rDNA identification
提取单菌的基因组DNA,以DNA作为模板进行16S rDNA扩增,采用16S rDNA的通用引物(8F-AGAGTTTGATCATGGCTCAG(SEQ ID NO.:2)和1492R-TAGGGTTACCTTGTTACGACTT(SEQID NO.:3))(购自生工生物工程(上海)股份有限公司),扩增条件是95℃预变性4min,然后95℃变性30s,57℃退火40s,72℃延伸1min30s,30个循环。扩增的PCR产物进行纯化,3730测序,获得每株菌的16S rDNA全长序列。其中AF04-45的16S rDNA序列长度为1399bp,如SEQID NO.:1所示。通过在NCBI的数据库比对,可以得出AF04-45同数据库中参考菌株Anaerostipes caccae(粪厌氧棒杆菌)DSMZ 14662(购自德国微生物菌种保藏中心,保藏号为DSMZ 14662)的16S rDNA相似度最高为100%。通过16S rDNA鉴定,基本可以确认AF04-45属于粪厌氧棒杆菌。The genomic DNA of the single bacteria was extracted, and the 16S rDNA was amplified using DNA as a template, using the universal primers of 16S rDNA (8F-AGAGTTTGATCATGGCTCAG (SEQ ID NO.: 2) and 1492R-TAGGGTTACCTTGTTACGACTT (SEQ ID NO.: 3)) (purchased from raw materials) The amplification conditions were pre-denaturation at 95°C for 4 min, followed by 30 cycles of denaturation at 95°C for 30s, annealing at 57°C for 40s, and extension at 72°C for 1 min for 30s. The amplified PCR products were purified and sequenced at 3730 to obtain the full-length 16S rDNA sequence of each strain. The 16S rDNA sequence of AF04-45 has a length of 1399 bp, as shown in SEQ ID NO.: 1. By comparing with the database of NCBI, it can be concluded that AF04-45 is similar to the 16S rDNA of the reference strain Anaerostipes caccae (Corynebacterium faecalis) DSMZ 14662 (purchased from the German Collection of Microorganisms, the deposit number is DSMZ 14662) in the database Degree up to 100%. Through 16S rDNA identification, it can be basically confirmed that AF04-45 belongs to Corynebacterium faecalis.
AF04-45的16S rDNA序列为SEQ ID NO.:1,如下所示:The 16S rDNA sequence of AF04-45 is SEQ ID NO.: 1, as follows:
1.3 AF04-45的微生物特征和生理生化特征1.3 Microbial and physiological and biochemical characteristics of AF04-45
(1)菌落形态(1) Colony morphology
AF04-45在PYG平板上37℃培养2天的菌落为淡黄色,凸起,较粘稠,不透明,近圆形,边缘整齐,直径约2-3mm(图1)。The colonies of AF04-45 cultured at 37°C for 2 days on PYG plates were pale yellow, raised, viscous, opaque, nearly round, with neat edges and a diameter of about 2-3mm (Figure 1).
(2)菌体显微形态(2) Microscopic morphology of bacteria
显微镜下放大1000倍AF04-45的菌体为杆状,革兰氏阴性,不产芽孢和鞭毛(图2)。The thalline of AF04-45 magnified 1000 times under the microscope was rod-shaped, gram-negative, and did not produce spores and flagella (Fig. 2).
(3)生理生化特征(3) Physiological and biochemical characteristics
AF04-45为过氧化氢酶阴性,氧化酶阴性,严格厌氧,在0.3%的胆盐中4h的存活率高达100%。AF04-45的底物利用情况API 20A实验结果如下表2:AF04-45 is catalase-negative, oxidase-negative, strictly anaerobic, and has a 4-h survival rate of up to 100% in 0.3% bile salts. The substrate utilization of AF04-45 API 20A experimental results are shown in Table 2 below:
表2Table 2
实施例2粪厌氧棒杆菌Anaerostipes caccae AF04-45的生物活性物质Example 2 The biologically active substance of Corynebacterium faecalis Anaerostipes caccae AF04-45
AF04-45的生物活性物质主要考察短链脂肪酸(SCFA)和有机酸产生情况。The bioactive substances of AF04-45 mainly investigated the production of short-chain fatty acids (SCFA) and organic acids.
(1)样品预处理(1) Sample pretreatment
将AF04-45培养48h,取1ml菌液进行12000r/min离心5min,取上清,准备进行短链脂肪酸(SCFA)和有机酸的检测。AF04-45 was cultured for 48h, 1ml of bacterial liquid was taken and centrifuged at 12000r/min for 5min, the supernatant was taken, and the detection of short chain fatty acids (SCFA) and organic acids was carried out.
(2)SCFA的测定(2) Determination of SCFA
短链脂肪酸的测定采用外标法,选用乙酸、丙酸、丁酸、戊酸进行标准曲线的制作。采用安捷伦气象色谱仪(GC-7890B,Agilent),选用HP-INNOWax(Cross-Linked PEG),30m×0.25mm×0.25um的毛细柱进行分析,检测器为氢火焰离子检测器,GC参数设置为柱温:180~200℃;气化室温度:240℃;检测温度:210℃;进样量:2μL;载气流量:N2,50mL/min;氢气流量:50mL/min;空气流量:600~700ml/min。The determination of short-chain fatty acids adopts the external standard method, and acetic acid, propionic acid, butyric acid and valeric acid are used to make the standard curve. An Agilent gas chromatograph (GC-7890B, Agilent) was used, HP-INNOWax (Cross-Linked PEG), 30m×0.25mm×0.25um capillary column was used for analysis, the detector was a hydrogen flame ion detector, and the GC parameters were set as Column temperature: 180~200℃; gasification chamber temperature: 240℃; detection temperature: 210℃; injection volume: 2μL; carrier gas flow: N2 , 50mL/min; hydrogen flow rate: 50mL/min; air flow rate: 600 ~700ml/min.
测定得出SCFA产量为:乙酸2.24mmol/L,丁酸37.31mmol/L。The yield of SCFA was determined to be: acetic acid 2.24 mmol/L, butyric acid 37.31 mmol/L.
(3)有机酸的测定(3) Determination of organic acids
有机酸的检测标准品选用:3-甲基丁酸,戊酸,奎宁酸,乳酸,草酸,丙二酸,苯甲酸,马来酸,丁二酸,反富马酸,苹果酸,己二酸,酒石酸,莽草酸,柠檬酸,异柠檬酸和L-抗坏血酸。仍然采用安捷伦气象色谱仪(GC-7890B,Agilent),色谱柱选用122-5532G DB-5ms(40m×0.25mm×0.25um),柱温:270~290℃;进样口温度:250℃;气体流量:0.86ml/min。测得粪厌氧棒杆菌Anaerostipes caccae AF04-45有机酸的含量详见下表3:The detection standard of organic acid is selected: 3-methylbutyric acid, valeric acid, quinic acid, lactic acid, oxalic acid, malonic acid, benzoic acid, maleic acid, succinic acid, trans-fumaric acid, malic acid, hexamethylene Diacid, tartaric acid, shikimic acid, citric acid, isocitric acid and L-ascorbic acid. The Agilent gas chromatograph (GC-7890B, Agilent) was still used, the chromatographic column was 122-5532G DB-5ms (40m×0.25mm×0.25um), the column temperature: 270~290℃; the inlet temperature: 250℃; the gas Flow: 0.86ml/min. The measured content of the organic acid of Corynebacterium faecalis Anaerostipes caccae AF04-45 is shown in Table 3 below:
表3table 3
实施例3粪厌氧棒杆菌Anaerostipes caccae AF04-45的抗生素敏感情况The antibiotic susceptibility of
考察AF04-45对20种抗生素的敏感情况,将AF04-45培养至对数生长期,取100ul菌液进行平板(PYG培养基)涂布,涂抹均匀后贴上抗生素药敏片,37℃厌氧条件下培养48h。测量抑菌圈的直径,其结果详见表4。To investigate the sensitivity of AF04-45 to 20 kinds of antibiotics, cultivate AF04-45 to the logarithmic growth phase, take 100ul of bacterial liquid and spread it on a plate (PYG medium). Incubate for 48h under oxygen conditions. The diameter of the inhibition zone was measured, and the results are shown in Table 4.
表4Table 4
结果显示,AF04-45对这20种抗生素均比较敏感。The results showed that AF04-45 was sensitive to these 20 antibiotics.
实施例4粪厌氧棒杆菌Anaerostipes caccae AF04-45对溃疡性肠炎的缓解情况Embodiment 4 The relief situation of fecal anaerobic corynebacterium Anaerostipes caccae AF04-45 to ulcerative colitis
4.1灌胃菌株的准备4.1 Preparation of gavage strains
(1)AF04-45的培养:将AF04-45培养至稳定期(约24h),离心,收集菌体,使用PBS(PBS添加0.05%的半胱氨酸盐酸盐)进行悬浮,调整菌浓至109cfu/ml,备用。(1) Cultivation of AF04-45: Cultivate AF04-45 to a stable phase (about 24h), centrifuge, collect the cells, use PBS (PBS with 0.05% cysteine hydrochloride) to suspend, adjust the bacterial concentration to 109 cfu/ml for use.
(2)VSL#3的准备:溶解VSL#3(购自美国Sigma Tau)的菌粉至PBS(磷酸盐缓冲液)中,同样调整菌浓至109cfu/ml,备用。(2) Preparation of VSL# 3: Dissolve the bacterial powder of VSL# 3 (purchased from Sigma Tau, USA) into PBS (phosphate buffered saline), and adjust the bacterial concentration to 109 cfu/ml for use.
4.2试验小鼠的准备4.2 Preparation of experimental mice
(1)小鼠品系:实验小鼠采用C57b1/6小鼠(购自湖北医学实验动物中心),8周龄,体重21g±2g,小鼠饲养环境为SPF级,适应性喂养1周进行造模。(1) Mouse strain: C57b1/6 mice (purchased from Hubei Medical Laboratory Animal Center) were used as experimental mice, 8 weeks old, body weight 21g±2g, the mice were reared in SPF grade, and adaptively fed for 1 week. mold.
(2)造模方法:UC模型小鼠采用DSS造模法,持续给小鼠饮用0.15%的DSS(葡聚糖硫酸钠,分子量36000-50000)(购自美国MPBiomedicals)7天。(2) Modeling method: DSS modeling method was adopted for UC model mice, and 0.15% DSS (sodium dextran sulfate, molecular weight 36000-50000) (purchased from MP Biomedicals, USA) was continuously given to the mice for 7 days.
(3)实验分组:试验小鼠共48只,每组12只小鼠,包括模型组、AF04-45治疗组、VSL#3阳性药组、Control组(空白对照组),具体如下所示:(3) Experimental grouping: There were 48 experimental mice in total, 12 mice in each group, including model group, AF04-45 treatment group,
模型组:0.15%的DSS诱导7天,并灌胃PBSModel group: induced with 0.15% DSS for 7 days, and gavaged with PBS
AF04-45治疗组:0.15%的DSS诱导7天,并灌胃AF04-45益生菌(PBS悬浮的活菌,109cfu/ml)AF04-45 treatment group: 0.15% DSS was induced for 7 days, and AF04-45 probiotics (viable bacteria suspended in PBS, 109 cfu/ml) were administered by gavage
VSL#3阳性药组:0.15%的DSS诱导7天,并灌胃VSL#3益生菌(PBS悬浮的活菌,109cfu/ml)
Control组:正常饲喂,不进行DSS诱导Control group: normal feeding without DSS induction
4.3实验过程4.3 Experimental process
按照小鼠分组情况进行DSS诱导和灌胃干预,干预方法采用边造模边治疗,每天记录小鼠体重、饮食和饮水情况,同时观察小鼠的粪便性状及粪便隐血情况,分别在第1天、第3天、第5天和第7天计算小鼠的疾病活动指数(DAI),DAI评分详见表5。实验持续7天,益生菌和PBS的日灌胃量为200ul。实验结束后处死小鼠,所有小鼠取血、脱颈、取结肠、拍照、称重、量取结肠长度。结肠组织保存于-80℃冰箱和多聚甲醛中。DSS induction and gavage intervention were performed according to the grouping of mice. The intervention method was to use modeling while modeling. The body weight, diet and drinking water of the mice were recorded every day. At the same time, the fecal properties and fecal occult blood were observed. , 3 days, 5 days and 7 days to calculate the disease activity index (DAI) of the mice, and the DAI scores are shown in Table 5. The experiment lasted for 7 days, and the daily dose of probiotics and PBS was 200ul. After the experiment, the mice were sacrificed, and all the mice were blooded, removed from the neck, colonized, photographed, weighed, and the length of the colon was measured. Colon tissue was stored in a -80°C freezer and in paraformaldehyde.
表5table 5
DAI指数等于体重、大便性状以及大便隐血三个积分之和。The DAI index is equal to the sum of the three scores of body weight, stool characteristics and fecal occult blood.
4.4实验结果4.4 Experimental results
(1)小鼠的体重的变化(1) Changes in the body weight of mice
实验过程小鼠的体重记录见表6和图3。The body weight records of mice during the experiment are shown in Table 6 and Figure 3.
表6Table 6
表6的数据显示,随着DSS的诱导,小鼠的体重呈现下降趋势,到第5天后,DSS诱导的小鼠(模型组)相比Control组小鼠的体重出现显著的变化(*P<0.001),体重的下降是UC严重程度的一个指标之一,其中模型组的体重下降的最严重,在第7天AF04-45组小鼠和VSL#3组小鼠的体重显著高于模型组(▲P<0.05),说明AF04-45可以有效减缓UC小鼠体重的下降。The data in Table 6 shows that with the induction of DSS, the body weight of the mice showed a downward trend, and after the 5th day, the body weight of the DSS-induced mice (model group) showed a significant change compared with the control group (*P< 0.001), the weight loss is one of the indicators of the severity of UC, and the model group has the most severe weight loss. On the 7th day, the weight of the AF04-45 group and the
(2)小鼠的疾病活动指数(DAI)(2) Disease activity index (DAI) of mice
DAI指数等于体重、大便性状以及大便隐血三个积分之和,分别计算小鼠在第1、3、5、7天的DAI指数,结果如表7和图4所示。The DAI index is equal to the sum of the three integrals of body weight, stool characteristics and fecal occult blood. The DAI index of the mice on the 1st, 3rd, 5th, and 7th days was calculated respectively. The results are shown in Table 7 and Figure 4.
表7Table 7
随着DSS诱导,小鼠的DAI指数逐渐上升,到第7天小鼠的DAI值达到最高,Control组由于未进行DSS诱导,其DAI指数维持稳定,第5天和第7天的DAI同DSS诱导的小鼠(模型组)DAI存在显著性差异(**P<0.01)。在AF04-45和VSL#3的干预下,小鼠的疾病活动情况有一定的改善,第7天,AF04-45组和VSL#3组的DAI指数明显低于模型组(*P<0.5)。说明AF04-45可以明显改善UC的疾病症状,同时AF04-45组小鼠在第7天的DAI指数显著低于VSL#3组,由此可见,AF04-45对UC小鼠的疾病控制的更好。With the DSS induction, the DAI index of the mice gradually increased, and the DAI value of the mice reached the highest on the 7th day. The DAI index of the Control group remained stable due to no DSS induction. The DAI on the 5th and 7th days was the same as that of DSS. There were significant differences in DAI of induced mice (model group) (**P<0.01). Under the intervention of AF04-45 and
(3)小鼠结肠长度的变化(3) Changes in colon length in mice
实验结束后处死小鼠并进行解剖,取出小鼠的结肠组织,测量其长度。由于DSS诱导的UC模型,小鼠在结肠组织会发生一系列病变导致结肠缩短,因此结肠的长度变化也是评判小鼠溃疡性肠炎的严重程度的指标之一。通过测量各组小鼠的结肠长度结果如表8和图5所示。After the experiment, the mice were sacrificed and dissected, and the colon tissue of the mice was removed and its length was measured. Due to the DSS-induced UC model, mice will have a series of lesions in the colon tissue leading to colon shortening, so the length change of the colon is also one of the indicators to judge the severity of ulcerative colitis in mice. The results are shown in Table 8 and Figure 5 by measuring the colon length of mice in each group.
表8Table 8
结果显示,造模7天小鼠的结肠缩短比较严重,相对于模型组,正常小鼠的结肠长度要长于UC造模的模型小鼠(**P<0.01),通过AF04-45和VSL#3的干预,可以显著减缓小鼠的结肠缩短(*P<0.05)。说明AF04-45在控制UC小鼠结肠病变有良好的效果。The results showed that the colon shortening of mice after 7 days of modeling was more serious. Compared with the model group, the colon length of normal mice was longer than that of UC model mice (**P<0.01). By AF04-45 and VSL# The intervention of 3 can significantly slow down the colon shortening in mice (*P<0.05). This indicates that AF04-45 has a good effect on the control of colon lesions in UC mice.
实施例5含粪厌氧棒杆菌Anaerostipes caccae AF04-45的食品组合物Example 5 Food composition containing Corynebacterium faecalis Anaerostipes caccae AF04-45
原料配比如表9。The raw material ratio is shown in Table 9.
表9Table 9
按照上述配方比例混合牛奶、白糖,搅拌至完全混合,预热,20Mpa压力均质,90℃左右杀菌5-10分钟,冷却至40-43℃,混入保护剂维生素C,接种1-100×106cfu/g的Anaerostipes caccae AF04-45菌,即制成含Anaerostipes caccae AF04-45菌的食品组合物。Mix milk and sugar according to the above formula ratio, stir until completely mixed, preheat, homogenize under 20Mpa pressure, sterilize at about 90°C for 5-10 minutes, cool to 40-43°C, mix in protective agent vitamin C, inoculate 1-100×10 Anaerostipes caccae AF04-45 bacteria at6 cfu/g are prepared into food compositions containing Anaerostipes caccae AF04-45 bacteria.
实施例6含Anaerostipes caccae AF04-45的药物组合物Example 6 Pharmaceutical composition containing Anaerostipes caccae AF04-45
原料配比见表10。The raw material ratio is shown in Table 10.
表10Table 10
按照比例将乳糖、酵母粉、蛋白胨以纯净水混合均匀,预热到60-65℃,20Mpa压力均质,90℃左右杀菌20-30分钟,冷却至36-38℃,混入保护剂维生素C,接入Anaerostipescaccae AF04-45活菌(1-50×106cfu/mL),36-38℃发酵至pH值为6.0,离心,冷冻干燥至水份含量小于3%,即制备Anaerostipes caccae AF04-45菌冷冻干燥物。称取0.5克Anaerostipes caccae AF04-45冷冻干燥物与麦芽糊精等量混合后装入胶囊中,即制成含Anaerostipes caccae AF04-45的药物组合物。Mix lactose, yeast powder and peptone with pure water according to the proportion, preheat to 60-65℃, homogenize under 20Mpa pressure, sterilize at about 90℃ for 20-30 minutes, cool to 36-38℃, mix with protective agent vitamin C, Insert Anaerostipes caccae AF04-45 viable bacteria (1-50×106 cfu/mL), ferment at 36-38°C to pH 6.0, centrifuge, and freeze-dry to a moisture content of less than 3% to prepare Anaerostipes caccae AF04-45 Bacteria freeze-dried product. 0.5 g of Anaerostipes caccae AF04-45 freeze-dried product is weighed and mixed with maltodextrin in equal amounts and then packed into capsules to prepare a pharmaceutical composition containing Anaerostipes caccae AF04-45.
实施例7含粪厌氧棒杆菌Anaerostipes caccae AF04-45的药物的制备Example 7 Preparation of the medicine containing Corynebacterium faecalis Anaerostipes caccae AF04-45
7.1菌液准备:将Anaerostipes caccae AF04-45(1×109cfu/ml)进行厌氧培养,厌氧培养基采用实施例1的PYG培养基,经过37℃厌氧发酵2-3天。7.1 Bacterial liquid preparation: Anaerostipes caccae AF04-45 (1×109 cfu/ml) was anaerobic cultured, the anaerobic medium was the PYG medium of Example 1, and anaerobic fermentation was carried out at 37° C. for 2-3 days.
7.2生长因子制备:将脱脂牛奶、酪蛋白进行混合、离心、超滤获得牛奶生长因子粗提物(含有维生素类物质、嘌呤类物质、和/或嘧啶类物质的营养物质)。7.2 Preparation of growth factors: Mix skim milk and casein, centrifuge and ultrafilter to obtain crude milk growth factor extracts (nutrients containing vitamins, purines, and/or pyrimidines).
7.3药物剂型制作:将5体积生长因子和1体积的保护剂维生素C加入到100体积的AF04-45发酵的菌液中,充分搅拌混匀,然后加入淀粉辅料(如麦芽糊精),从而制备得到含粪厌氧棒杆菌Anaerostipes caccae AF04-45的药物。7.3 Preparation of pharmaceutical dosage form: Add 5 volumes of growth factor and 1 volume of protective agent vitamin C to 100 volumes of AF04-45 fermented bacterial liquid, stir and mix well, and then add starch auxiliary materials (such as maltodextrin) to prepare A medicine containing Corynebacterium faecalis Anaerostipes caccae AF04-45 was obtained.
菌种保藏strain preservation
本发明的菌种粪厌氧棒杆菌Anaerostipes caccae AF04-45(与保藏名称相同)已于2016年10月13日保藏在广东省微生物菌种保藏中心,地址:广州市先烈中路100号大院59号楼5楼,保藏号:GDMCC No.:60088。The strain of the present invention, Anaerostipes caccae AF04-45 (same as the deposit name), has been deposited in the Guangdong Provincial Microbial Culture Collection Center on October 13, 2016, address: No. 59, Yard, No. 100, Middle Xianlie Road, Guangzhou 5th Floor, Building No.: GDMCC No.: 60088.
本发明提及的所有文献都在本申请中引用作为参考,就如同每一篇文献被单独引用作为参考那样。此外应理解,在阅读了本发明的上述讲授内容之后,本领域技术人员可以对本发明作各种改动或修改,这些等价形式同样落于本申请所附权利要求书所限定的范围。All documents mentioned herein are incorporated by reference in this application as if each document were individually incorporated by reference. In addition, it should be understood that after reading the above teaching content of the present invention, those skilled in the art can make various changes or modifications to the present invention, and these equivalent forms also fall within the scope defined by the appended claims of the present application.
序列表 sequence listing
<110> 深圳华大基因研究院<110> Shenzhen Huada Gene Research Institute
<120> 粪厌氧棒杆菌(Anaerostipes caccae)及其应用<120> Fecal anaerobic corynebacterium (Anaerostipes caccae) and its application
<130> P2019-0500<130> P2019-0500
<160> 1<160> 1
<170> SIPOSequenceListing 1.0<170> SIPOSequenceListing 1.0
<210> 1<210> 1
<211> 1399<211> 1399
<212> DNA<212> DNA
<213> 粪厌氧棒杆菌(Anaerostipes caccae AF04-45)<213> Corynebacterium faecalis (Anaerostipes caccae AF04-45)
<400> 1<400> 1
gaagcattta ggattgaagt tttcggatgg atttcctata tgactgagtg gcggacgggt 60gaagcattta ggattgaagt tttcggatgg atttcctata tgactgagtg gcggacgggt 60
gagtaacgcg tggggaacct gccctataca gggggataac agctggaaac ggctgctaat 120gagtaacgcg tggggaacct gccctataca gggggataac agctggaaac ggctgctaat 120
accgcataag cgcacagaat cgcatgattc agtgtgaaaa gccctggcag tataggatgg 180accgcataag cgcacagaat cgcatgattc agtgtgaaaa gccctggcag tataggatgg 180
tcccgcgtct gattagctgg ttggtgaggt aacggctcac caaggcgacg atcagtagcc 240tcccgcgtct gattagctgg ttggtgaggt aacggctcac caaggcgacg atcagtagcc 240
ggcttgagag agtgaacggc cacattggga ctgagacacg gcccaaactc ctacgggagg 300ggcttgagag agtgaacggc cacattggga ctgagacacg gcccaaactc ctacgggagg 300
cagcagtggg gaatattgca caatggggga aaccctgatg cagcgacgcc gcgtgagtga 360cagcagtggg gaatattgca caatggggga aaccctgatg cagcgacgcc gcgtgagtga 360
agaagtattt cggtatgtaa agctctatca gcagggaaga aaacagacgg tacctgacta 420agaagtattt cggtatgtaa agctctatca gcagggaaga aaacagacgg tacctgacta 420
agaagccccg gctaactacg tgccagcagc cgcggtaata cgtagggggc aagcgttatc 480agaagccccg gctaactacg tgccagcagc cgcggtaata cgtagggggc aagcgttatc 480
cggaattact gggtgtaaag ggtgcgtagg tggcatggta agtcagaagt gaaagcccgg 540cggaattact gggtgtaaag ggtgcgtagg tggcatggta agtcagaagt gaaagcccgg 540
ggcttaaccc cgggactgct tttgaaactg tcatgctgga gtgcaggaga ggtaagcgga 600ggcttaaccc cgggactgct tttgaaactg tcatgctgga gtgcaggaga ggtaagcgga 600
attcctagtg tagcggtgaa atgcgtagat attaggagga acaccagtgg cgaaggcggc 660attcctagtg tagcggtgaa atgcgtagat attaggagga acaccagtgg cgaaggcggc 660
ttactggact gtcactgaca ctgatgcacg aaagcgtggg gagcaaacag gattagatac 720ttactggact gtcactgaca ctgatgcacg aaagcgtggg gagcaaacag gattagatac 720
cctggtagtc cacgccgtaa acgatgaata ctaggtgtcg gggccgtaga ggcttcggtg 780cctggtagtc cacgccgtaa acgatgaata ctaggtgtcg gggccgtaga ggcttcggtg 780
ccgcagcaaa cgcagtaagt attccacctg gggagtacgt tcgcaagaat gaaactcaaa 840ccgcagcaaa cgcagtaagt attccacctg gggagtacgt tcgcaagaat gaaactcaaa 840
ggaattgacg gggacccgca caagcggtgg agcatgtggt ttaattcgaa gcaacgcgaa 900ggaattgacg gggacccgca caagcggtgg agcatgtggt ttaattcgaa gcaacgcgaa 900
gaaccttacc tggtcttgac atcccaatga ccgaacctta accggttttt tctttcgaga 960gaaccttacc tggtcttgac atcccaatga ccgaacctta accggttttt tctttcgaga 960
cattggagac aggtggtgca tggttgtcgt cagctcgtgt cgtgagatgt tgggttaagt 1020cattggagac aggtggtgca tggttgtcgt cagctcgtgt cgtgagatgt tgggttaagt 1020
cccgcaacga gcgcaacccc tatctttagt agccagcatt taaggtgggc actctagaga 1080cccgcaacga gcgcaacccc tatctttagt agccagcatt taaggtgggc actctagaga 1080
gactgccagg gataacctgg aggaaggtgg ggacgacgtc aaatcatcat gccccttatg 1140gactgccagg gataacctgg aggaaggtgg ggacgacgtc aaatcatcat gccccttatg 1140
gccagggcta cacacgtgct acaatggcgt aaacaaaggg aagcgaagtc gtgaggcgaa 1200gccagggcta cacacgtgct acaatggcgt aaacaaaggg aagcgaagtc gtgaggcgaa 1200
gcaaatccca gaaataacgt ctcagttcgg attgtagtct gcaactcgac tacatgaagc 1260gcaaatccca gaaataacgt ctcagttcgg attgtagtct gcaactcgac tacatgaagc 1260
tggaatcgct agtaatcgtg aatcagaatg tcacggtgaa tacgttcccg ggtcttgtac 1320tggaatcgct agtaatcgtg aatcagaatg tcacggtgaa tacgttcccg ggtcttgtac 1320
acaccgcccg tcacaccatg ggagtcagta acgcccgaag tcagtgaccc aaccgcaagg 1380acaccgcccg tcacaccatg ggagtcagta acgcccgaag tcagtgaccc aaccgcaagg 1380
agggagctgc cgaaggtgg 1399agggagctgc cgaaggtgg 1399
| Application Number | Priority Date | Filing Date | Title |
|---|---|---|---|
| PCT/CN2016/109690WO2018107365A1 (en) | 2016-12-13 | 2016-12-13 | Anaerostipes caccae and applications thereof |
| Publication Number | Publication Date |
|---|---|
| CN110062806A CN110062806A (en) | 2019-07-26 |
| CN110062806Btrue CN110062806B (en) | 2022-08-05 |
| Application Number | Title | Priority Date | Filing Date |
|---|---|---|---|
| CN201680091523.9AActiveCN110062806B (en) | 2016-12-13 | 2016-12-13 | Fecal anaerobic corynebacterium (Anaerostipes caccae) and its application |
| Country | Link |
|---|---|
| CN (1) | CN110062806B (en) |
| WO (1) | WO2018107365A1 (en) |
| Publication number | Priority date | Publication date | Assignee | Title |
|---|---|---|---|---|
| CA3118679A1 (en)* | 2018-11-05 | 2020-05-14 | The University Of Chicago | Methods and compositions for treating infectious, autoimmune, and allergic disease |
| CN111117925B (en)* | 2020-01-13 | 2021-05-25 | 浙江大学 | Anaerostipes sp B2131 and its application in inflammatory bowel disease |
| WO2024160742A1 (en)* | 2023-01-30 | 2024-08-08 | Mrm Health N.V. | Microbial compositions for treating joint inflammation |
| CN119193372B (en)* | 2024-09-09 | 2025-05-16 | 中国农业大学 | A fecal anaerobic coryneform bacteria strain CML199, a biological agent and its application in preparing a product for improving laying hen performance |
| Publication number | Priority date | Publication date | Assignee | Title |
|---|---|---|---|---|
| WO2004085628A1 (en)* | 2003-03-27 | 2004-10-07 | Rowett Research Institute | Lactic acid utilising bacteria and their therapeutic use |
| CN102325464A (en)* | 2009-02-23 | 2012-01-18 | 根特大学 | Methods and new strains for alleviating bowel problems |
| WO2012142605A1 (en)* | 2011-04-15 | 2012-10-18 | Samaritan Health Services | Rapid recolonization deployment agent |
| CN104160014A (en)* | 2011-12-01 | 2014-11-19 | 国立大学法人东京大学 | Human-derived bacteria that induce the proliferation or accumulation of regulatory T cells |
| CN104546933A (en)* | 2014-09-30 | 2015-04-29 | 深圳华大基因科技有限公司 | Application of bacteroides caccae in treatment or prevention of rheumatoid arthritis or related diseases thereof |
| Publication number | Priority date | Publication date | Assignee | Title |
|---|---|---|---|---|
| WO2011151941A1 (en)* | 2010-06-04 | 2011-12-08 | 国立大学法人東京大学 | Composition having activity of inducing proliferation or accumulation of regulatory t cell |
| Publication number | Priority date | Publication date | Assignee | Title |
|---|---|---|---|---|
| WO2004085628A1 (en)* | 2003-03-27 | 2004-10-07 | Rowett Research Institute | Lactic acid utilising bacteria and their therapeutic use |
| CN102325464A (en)* | 2009-02-23 | 2012-01-18 | 根特大学 | Methods and new strains for alleviating bowel problems |
| WO2012142605A1 (en)* | 2011-04-15 | 2012-10-18 | Samaritan Health Services | Rapid recolonization deployment agent |
| CN104160014A (en)* | 2011-12-01 | 2014-11-19 | 国立大学法人东京大学 | Human-derived bacteria that induce the proliferation or accumulation of regulatory T cells |
| CN104546933A (en)* | 2014-09-30 | 2015-04-29 | 深圳华大基因科技有限公司 | Application of bacteroides caccae in treatment or prevention of rheumatoid arthritis or related diseases thereof |
| Title |
|---|
| Isolation of lactate-utilizing butyrate-producing bacteria from humanfeces andin vivo administration ofAnaerostipes caccae strainL2 and galacto-oligosaccharides ina ratmodel;Tadashi Sato et al.;《FEMS Microbiol Ecol》;20080612;528-536* |
| 丁酸和叶酸预防与治疗肠道疾病及其分子基础;李雄彪等;《世界华人消化杂志》;20061118;3071-3080* |
| 人和动物胃肠道微生物丁酸合成途径相关酶基因的研究进展;李劲亭等;《微生物学报》;20121004;1181-1186* |
| Publication number | Publication date |
|---|---|
| CN110062806A (en) | 2019-07-26 |
| WO2018107365A1 (en) | 2018-06-21 |
| Publication | Publication Date | Title |
|---|---|---|
| CN111280252B (en) | Bifidobacterium longum subspecies, compositions containing them and uses thereof | |
| JP6990303B2 (en) | MEGAMONAS FUNIFORMIS and its applications | |
| CN110062806B (en) | Fecal anaerobic corynebacterium (Anaerostipes caccae) and its application | |
| CN112888448B (en) | Use of megamonas simplex for preventing and/or treating metabolic diseases | |
| CN106974262A (en) | Application of the prebiotic bacillus of enteron aisle in fat and its relevant disease is treated and prevented | |
| CN106994134A (en) | Application of the beneficial bacteria of intestinal tract in preventing and/or treating diabetes and its relevant disease | |
| CN106479906B (en) | Intestinal bacterium butyric acid bacillus (Butyribacter intestini) and application thereof | |
| CN117645955A (en) | Eubacterium rectum with function of promoting recovery of intestinal epithelial cells and application thereof | |
| WO2018112739A1 (en) | Bifidobacterium pseudocatenulatum, culture method therefor and application thereof | |
| CN111281894A (en) | Use and composition of lactobacillus gasseri for preventing and/or treating metabolic diseases | |
| CN111093682B (en) | Use of butyric acid bacilli (Butyribacter intestini) for preventing and/or treating diseases related to inflammation | |
| US20190240264A1 (en) | Faecalibacterium longum and application thereof | |
| WO2019227414A1 (en) | Composition and uses thereof | |
| CN111448306B (en) | Anaerofustis stercorihominis and its applications | |
| WO2018107364A1 (en) | Collinsella shenzhenensis and applications thereof | |
| CN112867500B (en) | Use of human manure anaerobism coryneform bacteria in preventing and/or treating metabolic diseases | |
| CN106974939B (en) | Application of Firmicutes probiotics in the treatment and prevention of obesity and related diseases | |
| HK40000533A (en) | Megamonas funiformis and applications thereof | |
| CN120210043A (en) | Bifidobacterium bifidum and composition thereof | |
| CN120158394A (en) | Bifidobacterium longum subspecies longum FN103 and composition thereof | |
| HK40017896A (en) | Use of butyribacter intestini in preventing and/or treating inflammation-related diseases | |
| HK40042147A (en) | Composition and uses thereof | |
| HK1240096B (en) | Application of intestinal probiotics in preventing and/or treating diabetes and related diseases thereof | |
| HK1239564A1 (en) | Application of thick-wall fungus probiotics in treatment and prevention of obesity and related diseases | |
| CN107080756A (en) | Application of the streptococcus probiotics in preventing and/or treating diabetes and its relevant disease |
| Date | Code | Title | Description |
|---|---|---|---|
| PB01 | Publication | ||
| PB01 | Publication | ||
| SE01 | Entry into force of request for substantive examination | ||
| SE01 | Entry into force of request for substantive examination | ||
| GR01 | Patent grant | ||
| GR01 | Patent grant |